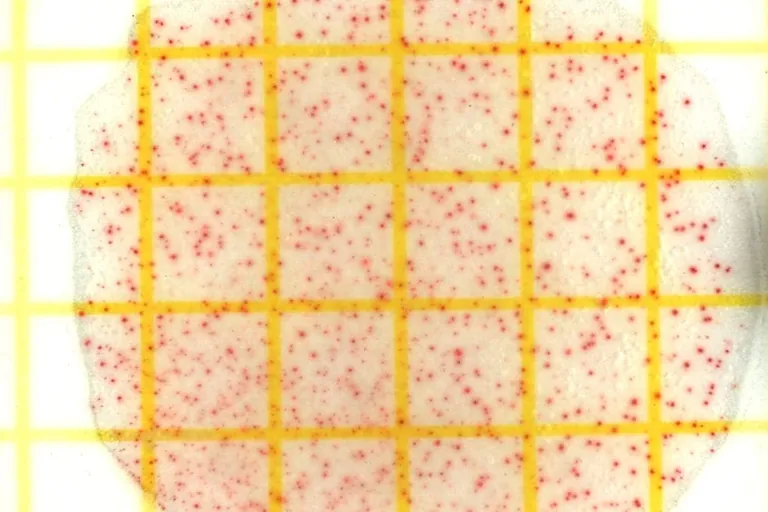
Lactobazillen

Laktobazillen sind stäbchenförmige, mikroaerophile Milchsäurebakterien. Das heißt die Bakterien verwerten Zucker zu Milchsäure, bevorzugt in einer Atmosphäre mit reduziertem Sauerstoffangebot.
Die Fähigkeit, Milchsäure aus Zuckerstoffen bilden zu können, nutzen wir bei der Reifung von Rohwürsten aus, weshalb Laktobazillen in den meisten Starterkulturmischungen für Rohwürste enthalten sind.
Neben diesen, sogenannten homofermentativen Laktobazillen, die ausschließlich Milchsäure bilden, gibt es auch heterofermentative Laktobazillen. Diese bilden nicht nur die gewünschte Milchsäure, sondern zusätzlich auch noch Essigsäure und Kohlendioxid.
Wenn sich heterofermentative Laktobazillen in der Rohwurst stark vermehren können, kann es zu Geschmacksabweichungen durch zu starke Säuerung und die Bildung von Peroxiden kommen sowie zu Porigkeit der Wurst durch Gasbildung.
Durch den Einsatz von geeigneten Starterkulturen lässt sich die Mikroorganismenflora in unseren Produkten beeinflussen und in die eine oder andere Richtung lenken. Insgesamt tragen Starterkulturen besonders bei Rohwurst und Rohpökelwaren zur Produktsicherheit bei.
